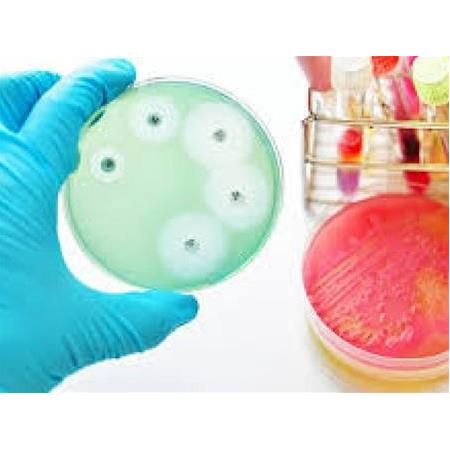

NANOKAR
(+90) 216 526 04 90
Pendik / İstanbul
info@nanokar.com
- 3D Yazıcı Tozlar 1616 ürün
- Nikel Alaşım Tozlar 88 ürün
- Titanyum Alaşım Tozlar 88 ürün
- Grafen Nanopartiküller 4343 ürün
- CVD Grafen 22 ürün
- Dispersiyonlar 33 ürün
- Grafen Oksit Sulu Çözeltisi Tozlar 22 ürün
- Grafen Sulu Çözeltisi Tozlar 11 ürün
- Fullerene 44 ürün
- Fulleren- C70 Tozlar 22 ürün
- Fulleren-C60 Tozlar 22 ürün
- Grafen Aerojeller 1414 ürün
- Güçlü Grafen Aerojel 22 ürün
- Karbon Nanotüp (CNT) Modifiye Grafen Aerojel 22 ürün
- Manyetik Grafen Aerojel 44 ürün
- Nikel Grafen Köpük 44 ürün
- Ultra Hafif Grafen Aerojel 22 ürün
- Grafen Levhalar 55 ürün
- Grafen Levha 55 ürün
- Grafen Oksitler 55 ürün
- Grafen Oksit Tozlar 33 ürün
- Kimyasal İndirgenmiş Grafen Oksit Tozlar 11 ürün
- Termal İndirgenmiş Grafen Oksit Tozlar 11 ürün
- Nano Grafenler 1010 ürün
- Grafen Katkılı Bakır Tozlar 11 ürün
- Nano Grafen Tozlar 99 ürün
- Nano Bileşik Tozlar 88 ürün
- Bor Nitrür Tozlar 33 ürün
- Nano Hidroksiapatit Tozlar 11 ürün
- Nano Selüloz Kristalin Tozlar 11 ürün
- Politetrafloroetil Tozlar 11 ürün
- Silisyum Karbür Tozlar 11 ürün
- Titanyum Nitrür Tozlar 11 ürün
- Karbon Nanotüpler 8686 ürün
- Tek Duvarlı Nanotüpler 1313 ürün
- (-COOH) Fonksiyonlaştırılmış Kısa Tek Duvarlı Karbon Nanotüp Tozlar 22 ürün
- (-COOH) Fonksiyonlaştırılmış Tek Duvarlı Karbon Nanotüp Tozlar 22 ürün
- (-OH) Fonksiyonlaştırılmış Kısa Tek Duvarlı Karbon Nanotüp Tozlar 11 ürün
- (-OH) Fonksiyonlaştırılmış Tek Duvarlı Karbon Nanotüp Tozlar 22 ürün
- Karbon Siyahı Ve Karbon Nanotüp Tozlar 11 ürün
- Kısa Tek Duvarlı Karbon Nanotüp Tozlar 11 ürün
- Tek Duvarlı Karbon Nanotüp Tozlar 33 ürün
- Yüksek Yüzey Alanlı Tek Duvarlı Karbon Nanotüp Tozlar 11 ürün
- Çift Duvarlı Nanotüpler 77 ürün
- (-COOH) Fonksiyonlaştırılmış Kısa Boylu Çift Duvarlı Karbon Nanotüp Tozlar 11 ürün
- (-COOH) ile Fonksiyonlaştırılmış Çift Duvarlı Karbon Nanotüp Tozlar 11 ürün
- (-OH) Fonksiyonlaştırılmış Kısa Boylu Çift Duvarlı Karbon Nanotüp, Saflık: > 65% 11 ürün
- (-OH) ile Fonksiyonlaştırılmış Çift Duvarlı Karbon Nanotüp Tozlar 11 ürün
- Çift Duvarlı Karbon Nanotüp Tozlar 11 ürün
- Karbon Siyahı Ve Karbon Nanotüp Tozlar 11 ürün
- Kısa Boylu Çift Duvarlı Karbon Nanotüp Tozlar 11 ürün
- Çok Duvarlı Nanotüpler 88 ürün
- Özel Karbon Nanotüpler 5858 ürün
- (-COOH) Fonksiyonlaştırılmış Çok Duvarlı Karbon Nanotüp Tozlar 22 ürün
- Amino-Çok Duvarlı Karbon Nanotüp Tozlar 11 ürün
- CNT'ler - Yüksek Etkili Polistiren Reçine Matrix Tozlar 11 ürün
- Çok Duvarlı Karbon Nanotüp, Flash-Ignited Tozlar 11 ürün
- Çok Duvarlı Karbon Nanotüp, Kuvars Üzerinde Sıralanmış Tozlar 33 ürün
- Çok Duvarlı Karbon Nanotüp, Monokristal Silikon Üzerinde Sıralanmış Tozlar 33 ürün
- Çok Duvarlı Karbon Nanotüp, Polikristal Silikon Üzerinde Sıralanmış Tozlar 11 ürün
- Geniş İç Çaplı İnce Çok Duvarlı Karbon Nanotüp Tozlar 11 ürün
- Karbon NanoTubes Alüminyum Tozlar 55 ürün
- Karbon Nanotüp Bucky Paper Metal Katkılı Tozlar 11 ürün
- Karbon Nanotüp Katkılanmış Gümüş Tozlar 33 ürün
- Karbon Nanotüp Metal Bant Tozlar 22 ürün
- Karbon Nanotüp Metal Film Tozlar 22 ürün
- Karbon Nanotüp Yüksek İletken Bant Metal Katkılı Tozlar 11 ürün
- Karbon Nanotüp Yüksek İletken Film Metal Katkılı Tozlar 11 ürün
- Karbon Nanotüp-Temelli İletkenlik Arttırıcı Tozlar 11 ürün
- Karbon Siyahı Ve Karbon Nanotüp Tozlar 11 ürün
- Katkılanmış Karbon Nanotüp Bakır Tozlar 33 ürün
- Katkılanmış Karbon Nanotüp Çinko Tozlar 11 ürün
- Katkılanmış Karbon Nanotüp Demir Tozlar 44 ürün
- Katkılanmış Karbon Nanotüp Grafen Tozlar 33 ürün
- Katkılanmış Karbon Nanotüp Kalay Tozlar 11 ürün
- Katkılanmış Karbon Nanotüp Kobalt Tozlar 11 ürün
- Katkılanmış Karbon Nanotüp Nitrür Tozlar 11 ürün
- Katkılanmış Karbon Nanotüp Silika Tozlar 11 ürün
- Katkılanmış Karbon Nanotüp Silikon Tozlar 33 ürün
- Katkılanmış Karbon Nanotüp Titanyum Tozlar 11 ürün
- Nitrojen Katkılı Çok Duvarlı Karbon Nanotüp Tozlar 11 ürün
- Sarmal Çok Duvarlı Karbon Nanotüp Tozlar 11 ürün
- Süper İletken Karbon Siyah Nanopartikül/Nanotoz ve Karbon Tozlar 11 ürün
- Tek Duvarlı Karbon Nanotüp, Kuvars Üzerinde Sıralanmış Tozlar 33 ürün
- Tek Duvarlı Karbon Nanotüp, Monokristal Silikon Üzerinde Sıralanmış Tozlar 22 ürün
- Tek Duvarlı Nanotüpler 1313 ürün
- Mikropartiküller 248248 ürün
- Nadir Toprak Elementler 2929 ürün
- Nadir Metal Tozlar 1515 ürün
- Nadir Toprak Oksitler 1414 ürün
- Oksit Tozlar 5555 ürün
- Alüminyum Hidroksit Tozlar 11 ürün
- Alüminyum Oksit Tozlar 88 ürün
- Antimon Oksit Tozlar 11 ürün
- Antimon Trioksit Tozlar 11 ürün
- Bakır Oksit Tozlar 11 ürün
- Baryum Karbonat Tozlar 11 ürün
- Bizmut Oksit Tozlar 22 ürün
- Bor Oksit Tozlar 11 ürün
- Borik Asit Tozlar 11 ürün
- Cam Elyaf Tozlar 11 ürün
- Çinko Oksit Tozlar 11 ürün
- Demir Oksit Tozlar 44 ürün
- Grafen Oksit Tozlar 22 ürün
- Gümüş Nitrat Tozlar 11 ürün
- Hafniyum Oksit Tozlar 11 ürün
- Kalay Oksit Tozlar 11 ürün
- Kalsiyum Karbonat Tozlar 11 ürün
- Kil Tozlar 11 ürün
- Kobalt Oksit Tozlar 33 ürün
- Krom Oksit Tozlar 11 ürün
- Kurşun Oksit Tozlar 11 ürün
- Kuvars Tozlar 11 ürün
- Lutesyum Oksit Tozlar 11 ürün
- Magnezyum Oksit Tozlar 11 ürün
- Mangan Oksit Tozlar 11 ürün
- Molibden Disülfür Tozlar 11 ürün
- Molibden Tozlar 11 ürün
- Nikel Oksit Tozlar 11 ürün
- Potasyum Feldspat Tozlar 11 ürün
- Seryum Oksit Tozlar 22 ürün
- Silisyum Dioksit Tozlar 33 ürün
- Talk Pudrası Tozlar 11 ürün
- Titandioksit Anatas Tozlar 11 ürün
- Titanyum Dioksit Rutile Tozlar 11 ürün
- Tungsten Trioksit Tozlar 11 ürün
- Vanadyum Pentoksit Tozlar 11 ürün
- Zeolit Tozlar 11 ürün
- Zirkonyum Silikat Tozlar 11 ürün
- Aşındırıcı Tozlar 4747 ürün
- Alüminyum Oksitler 77 ürün
- Bor Krabür Tozlar 77 ürün
- Bor Nitrür Tozlar 33 ürün
- Silisyum Karbür Tozlar 1616 ürün
- Tantal Karbür Tozlar 33 ürün
- Titanyum Diborür Tozlar 33 ürün
- Titanyum Karbür Tozlar 11 ürün
- Titanyum Nitrür Tozlar 22 ürün
- Tungsten Karbür Tozlar 33 ürün
- Zirkonyum Diborür Tozlar 11 ürün
- Ferro Alaşım Tozlar 2424 ürün
- Ferro Bor Tozlar 33 ürün
- Ferro Krom Tozlar 55 ürün
- Ferro Molibden Tozlar 33 ürün
- Ferro Niobyum Tozlar 22 ürün
- Ferro Silisyum Tozlar 33 ürün
- Ferro Titanyum Tozlar 33 ürün
- Ferro Vanadium Tozlar 22 ürün
- Ferro Wolfram Tozlar 33 ürün
- Metal Tozlar 9393 ürün
- Alüminyum Tozlar 1111 ürün
- Bakır Tozlar 1010 ürün
- Bizmut Tozlar 11 ürün
- Bor Tozlar 66 ürün
- Bronz Tozlar 22 ürün
- Çelik Tozlar 22 ürün
- Çinko Tozlar 33 ürün
- Demir Tozlar 1010 ürün
- Germanyum Tozlar 11 ürün
- Grafit tozlar 55 ürün
- Gümüş Tozlar 22 ürün
- Hafniyum Tozlar 11 ürün
- Infuzyon Epoksi Seti 11 ürün
- Kadmiyum Tozlar 11 ürün
- Kalay Tozlar 33 ürün
- Kobalt Tozlar 22 ürün
- Krom Tozlar 44 ürün
- Laminasyon Epoksi Seti 77 ürün
- Magnezyum Tozlar 33 ürün
- Mangan Tozlar 22 ürün
- Molibden Tozlar 11 ürün
- Nikel Tozlar 33 ürün
- Niyobyum Tozlar 22 ürün
- Pirinç Tozlar 22 ürün
- Seffaf Döküm Epoksi Seti 11 ürün
- Silisyum Tozlar 11 ürün
- Tantal Tozlar 11 ürün
- Titanyum Tozlar 22 ürün
- Tungsten Tozlar 22 ürün
- Zirkonyum Tozlar 11 ürün
- Nadir Toprak Elementler 2929 ürün
- Genel 11 ürün
- Nanopartiküller 106106 ürün
- Dispersiyonlar 1313 ürün
- Etilen Glikol Bazlı Kolloidal Alüminyum Oksit Çözeltisi 11 ürün
- Grafen Oksit Sulu Çözeltisi 22 ürün
- Grafen Sulu Çözeltisi 11 ürün
- Kolloidal Altın Çözeltisi 11 ürün
- Nano Gold Liquid 11 ürün
- Nano Silver Liquid 44 ürün
- Propanediol Bazlı Kolloidal Alüminyum Oksit 11 ürün
- Su Bazlı Kolloidal Alüminyum Oksit 22 ürün
- Nano Metal Tozlar 3737 ürün
- Kalay Tozlar 11 ürün
- Nano Altın Tozlar 22 ürün
- Nano Alüminyum Tozlar 33 ürün
- Nano Bakır Tozlar 44 ürün
- Nano Bizmut Tozlar 11 ürün
- Nano Bor Tozlar 55 ürün
- Nano Çinko Tozlar 33 ürün
- Nano Demir Tozlar 33 ürün
- Nano Grafit Tozlar 11 ürün
- Nano Gümüş Tozlar 44 ürün
- Nano Kobalt Tozlar 11 ürün
- Nano Kükürt Tozlar 11 ürün
- Nano Nikel Tozlar 22 ürün
- Nano Silisyum Tozlar 11 ürün
- Nano Titanyum Tozlar 22 ürün
- Nano Tungsten Tozlar 22 ürün
- Oksit Nanopartiküller 5656 ürün
- Alüminyum Nitrit Tozlar 11 ürün
- Bizmut Oksit Tozlar 11 ürün
- Bor Oksit Tozlar 11 ürün
- Hafniyum Oksit Tozlar 22 ürün
- İndiyum Hidroksit Tozlar 11 ürün
- İndiyum Kalay Oksit Tozlar 11 ürün
- Kobalt Oksit Tozlar 22 ürün
- Manganez Oksit Tozlar 11 ürün
- Molibden Trioksit Tozlar 11 ürün
- Nano Alüminyum Oksit Tozlar 55 ürün
- Nano Bakır Oksit Tozlar 44 ürün
- Nano Çinko Oksit Tozlar 22 ürün
- Nano Demir Oksit Tozlar 55 ürün
- Nano Kalsit Tozlar 11 ürün
- Nano Krom Oksit Tozlar 11 ürün
- Nano Magnezyum Oksit Tozlar 55 ürün
- Nano Nikel Oksit Tozlar 44 ürün
- Nano Silisyum Oksit Tozlar 33 ürün
- Nano Titanyum Dioksit Tozlar 1010 ürün
- Nanokil Tozlar 11 ürün
- Neodim Oksit Tozlar 11 ürün
- Seryum Oksit Tozlar 11 ürün
- Seryum Tungsten Oksit Tozlar 11 ürün
- Zirkonyum Oksit Tozlar 11 ürün
- Dispersiyonlar 1313 ürün